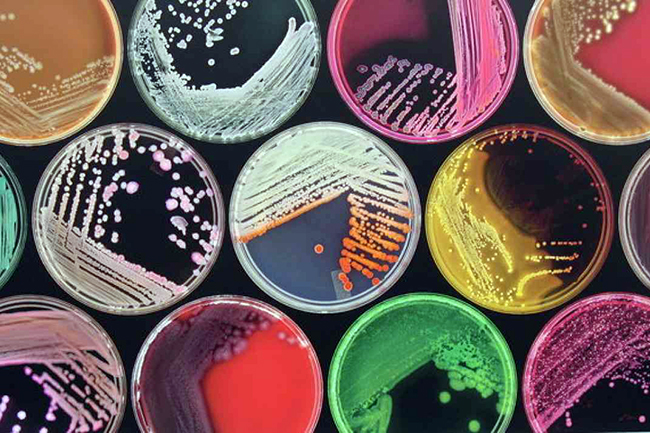

Мачји паразит токсоплазма уме да „репрограмира“ меморију људи и мишева
ПРВЕ - ТО ЈЕСТ ЉУДЕ - ЧИНИ СКЛОНИМ САМОУБИСТВУ, А ДРУГЕ - НЕУСТРАШИВИМ
- Гљиве из рода Ophiocordyceps су научиле да директно управљају понашањем мрава, терајући их да умиру на тачно одређеном месту изнад мравињака како би заразили што више нових жртава
- Mикроб-паразит волбахија (Wolbachia), којим је заражено око пола свих инсеката, манипулише њиховим полним понашањем и тера их да се размножавају чешће да би убрзао сопствено размножавање
- Бактерија Vibrio fischeri у своје окружење испушта посебан ензим, који делује на једноставна створења као прави „афродизијак“. Сличне материје користи и организам људи и других животиња током спајања сперматозоида и јајне ћелије и њеног оплођавања. Научници сматрају да су ти микроби-„афродизијаци“ могли да натерају наше претке да се одрекну дељења и пређу на полно размножавање
БИОЛОЗИ из Калифорније открили су необичну бактерију, која тера најједноставније једноћелијске животиње, далеке рођаке морских сунђера, да губе „осећај стида“ и претварају се у својеврсне „секс бомбе“, које стално ступају у реакцију размножавања са другим ћелијама.
Осим овога, последњих година биолози су открили много примера да паразити не само користе организам-домаћина, већ и директно управљају његовим понашањем. На пример, вирус LdMNPV уме да натера гусенице свилене бубе да се попну на врх дрвета и претворе у „вирусну бомбу“ која експлодира и заражава све око себе.
Ларве мува из рода Phoridae терају пчеле да беже из кошнице и понашају се попут „зомбија“, а гљиве из рода Ophiocordyceps су научиле да директно управљају понашањем мрава, терајући их да умиру на тачно одређеном месту изнад мравињака како би заразили што више нових жртава.
Мачји паразит токсоплазма уме да „репрограмира“ меморију људи и мишева, чинећи прве склоним самоубиству, а друге - неустрашивим.
Toxoplasma мишеве чини неустрашивм
Такви случајеви, како су на конференцији Америчког друштва за ћелијску биологију у Сан Франциску рекли Никол Кинг и Ариел Возница са универзитета Калифорније у Берклију (САД), наводе многе научнике да сматрају да постоје многи паразити и учесници симбиозе који, између осталог, управљају и полним понашањем домаћина.
Тако постоји сумња да микроб-паразит волбахија (Wolbachia), којим је заражено око пола свих инсеката, манипулише њиховим полним понашањем и тера их да се размножавају чешће да би убрзао сопствено размножавање.
Најједноставнији и најочигледнији пример такве тактике Кинг и Возница открили су пратећи понашање најједноставнијих животиња - једноћелијских створења Salpinogoeca rosetta, далеких рођака морских сунђера и вероватних рођака предака свих вишећелијских створења на Земљи.
Та једноставна створења обично живе у заједници, формирајући колоније од неколико стотина јединки. С времена на време ћелије се спајају једна с другом и деле се, али у нормалној ситуацији живе релативно мирно.
Како се испоставило, тј мир може да наруши бактерија Vibrio fischeri, која у своје окружење испушта посебан ензим, који делује на та једноставна створења, по речима научника, као прави „афродизијак“.
Бактерија Vibrio fischeri
Доспевање чак и малог броја тих молекула у колонију Salpinogoeca rosetta доводи до практично моменталног распада колоније, и формирања „ројева“ ћелија које се паре између себе, које прво дуплирају своје хромозоме, а затим их размењују са партнером.
Занимљиво је да сличне материје користи и организам људи и других животиња током спајања сперматозоида и јајне ћелије и њеног оплођавања. Научници сматрају да су ти микроби-„афродизијаци“ могли да натерају наше претке да се одрекну дељења и пређу на полно размножавање.
И на крају, откривање тако необичних односа између бактерија и најједноставнијих животиња говори да микроби заиста могу да „диригују“ тако сложеним облицима понашања као што је продужење врсте код вишећелијских и једноћелијских животиња.




















